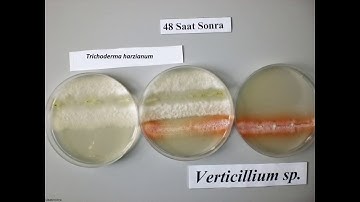
Trichoderma harzianum & Verticillium sp.

⬇ DOWNLOAD NOW
Kalau muncul iklan pop-up, tutup lalu klik tombol kembali
Download lagu VNFs - Trichoderma secara gratis hanya untuk keperluan promosi. Dukung artis favorit kamu dengan membeli musik original di iTunes atau platform resmi lainnya.
 How do Trichoderma work? Atens explain it to you
How do Trichoderma work? Atens explain it to you
 Trichoderma harzianum T22 combats Fusarium oxysporum in tomato
Trichoderma harzianum T22 combats Fusarium oxysporum in tomato
Trichoderma harzianum & Verticillium sp.
Trichoderma harzianum & Verticillium sp.
 Trichoderma Mold Fungi Timelapse
Trichoderma Mold Fungi Timelapse
 Trichoderma harzianum T22 combats Fusarium in maize roots – Koppert
Trichoderma harzianum T22 combats Fusarium in maize roots – Koppert
 Tricho Protect - Trichoderma Harzianum - Biofungicide
Tricho Protect - Trichoderma Harzianum - Biofungicide
 How to Use Trichoderma That You Never Know
How to Use Trichoderma That You Never Know
 Trichoderma harzianum T22 combats Fusarium in tomato – Koppert
Trichoderma harzianum T22 combats Fusarium in tomato – Koppert